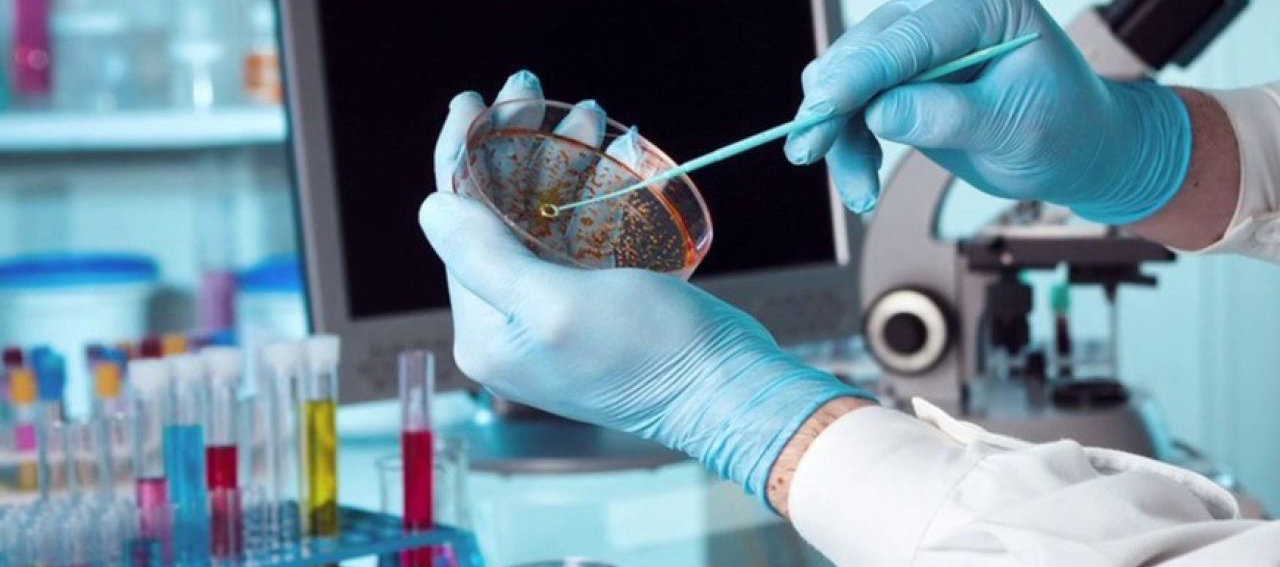

Microbiology

______________________________________________________________________________________________________________________________
Key Facts
Foundation
Total Duration
School of Medicine 24 Months
Curriculum
Commencement
September & February
_____________________________________________________________________________________________________________________________
About
Medical microbiology, the large subset of microbiology that is applied to medicine , is a
branch of medical science concerned with the prevention , diagnosis and treatment of
infectious diseases. In addition, this field of science studies various clinical applications
of microbes for the improvement of health .
______________________________________________________________________________________________________________________________
Requirements
B.Sc. or equivalent certification
Transcript of the records
Research proposal
Curriculum Vitae
A minimum score of 533 TOEFL PBT, 72 TOEFL iBT, 5.5 IELTS
_____________________________________________________________________________________________________________________________


